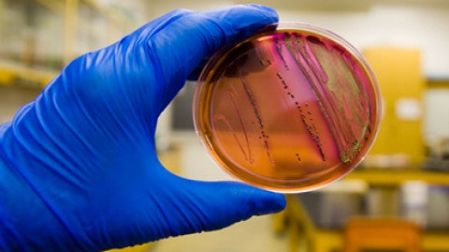
thumb

Alerta en EU por brote bacteriano; reportan 72 enfermos
Hasta el momento se han reportado 72 personas enfermas en cinco estados de Estados Unidos

ESTADOS UNIDOS.
Autoridades de salud de Estados Unidos investigan un brote de la bacteria Escherichia coli (E.coli) que afecta al menos a 72 personas en cinco entidades, de acuerdo con reportes de los centros para el Control y Prevención de Enfermedades (CDC).
El brote, que habría comenzado a inicios de marzo pasado, se ha extendido hasta ahora a Kentucky con 36 casos; Tennessee con 21; Georgia con ocho; Ohio con cinco; y Virginia con dos, detalló el CDC en un comunicado.
La cadena Univision informó que el primer caso fue detectado el 2 de marzo pasado y que las edades de los afectados varían de uno a 74 años, con una media de 17 años.

Las autoridades de salud investigan el origen del brote, e indicaron que a pesar que la mayor parte de las cepas de E. coli son inofensivas, para evitar infectarse es recomendable mantener una higiene adecuada, cocinar la carne a la temperatura recomendada y evitar la leche y productos lácteos sin pasteurizar.
Expertos citados por el periódico The Washington Post indicaron que la bacteria puede encontrarse en el ambiente, en la comida y los intestinos de las personas y animales.
Sin embargo, admitieron que por el momento el origen de este nuevo brote es "desconcertante".
El experto en seguridad alimentaria, Bill Marler, comentó al rotativo que sin duda las personas afectadas en este caso de E. coli debieron compartir una fuente común de la cepa, pero que son los CDC los que deben determinar qué producto, cadena de supermercados o restaurantes está en el origen.
Dado el tamaño y el número de estados involucrados, lo que estamos viendo es muy poco común", consideró el especialista.
Si fueran cinco o diez personas es un poco más difícil averiguarlo. Pero cuando hay 72 y están siendo entrevistados por epidemiólogos, es muy poco usual no tener una fuente" identificada de contaminacion, señaló Marler.
Alerta en EU; piden cuidar a las mascotas de fuertes vientos
emb



